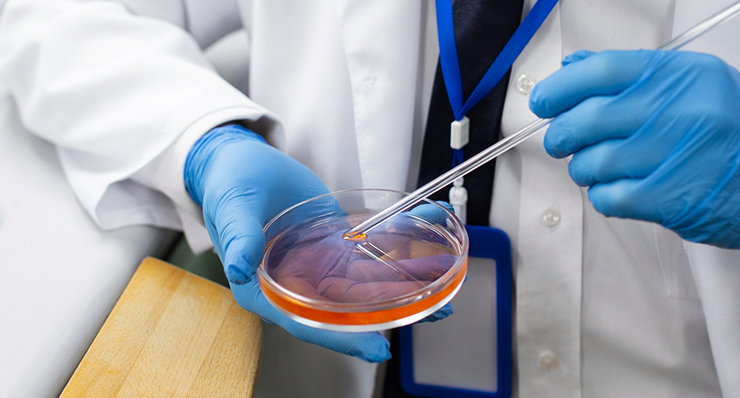
Image

At Fertility Center, we offer a full range of medical services to help you achieve your dream of parenthood. Our mission is to support and guide you on your journey to becoming happy parents. Whether you need egg donation or a gestational carrier, we are dedicated to making the process as seamless and stress-free as possible. Let us help you take the next step towards growing your family.
Successful
Pregnancies

Our IVF specialist is not only highly qualified but deeply compassionate. They provide personalized care and support, ensuring you feel understood and valued every step of the

At Fertility Center, we combine cutting-edge technology with compassionate care. Our state-of-the-art equipment ensures the highest standards of treatment, giving you the best possible chance of

We understand the profound emotional journey of reproductive challenges. Our dedicated team supports you through every hurdle, offering specialized treatments for various fertility


Gynecologist and Fertility Expert
MBBS, MS ( BSMMU, Dhaka )
Phone: +88 01747 546049
Email: [email protected]
Our brand-new reproductive center offers the latest fertility technology and comfort. We can help people with infertility and reproductive difficulties.
Our brand-new reproductive center offers the latest fertility technology and comfort. We can help people with infertility and reproductive difficulties.
Happy
Families
At Fertility Center, we provide the individualized care and attention you deserve on your journey to parenthood. Our comprehensive testing uncovers the causes of male and female infertility, allowing us to create a personalized treatment plan just for you. We specialize in advanced techniques like IUI and IVF, maximizing your chances of success.
Our clients recommend us because they feel genuinely cared for and supported. We celebrate every milestone with you, turning hopes and dreams into a beautiful reality. Choose us and start your journey to parenthood with confidence and hope.
Contact Us Online or Give Us a Call